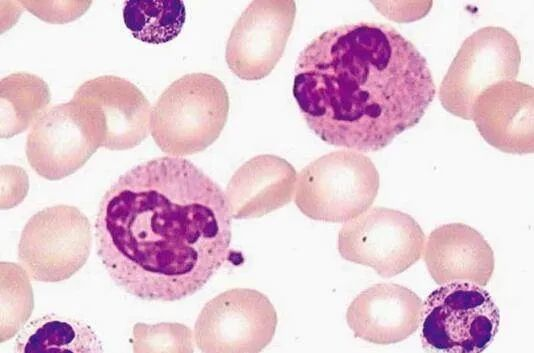

免疫細(xì)胞是我們身體中非常重要的一類細(xì)胞,它擔(dān)任著免疫監(jiān)視、造血、凝血等重要功能,具有免疫防御、免疫自穩(wěn)、免疫監(jiān)視的重要作用,以維護(hù)我們的健康免受疾病的侵襲。

免疫細(xì)胞作為人體的健康衛(wèi)士,每時(shí)每刻都在與數(shù)以億計(jì)的細(xì)菌、病毒、突變細(xì)胞、癌細(xì)胞等戰(zhàn)斗。免疫細(xì)胞可防止外來病原微生物對身體的侵襲,有效降低各種疾病的發(fā)生,同時(shí)能夠清除機(jī)體內(nèi)部的衰老細(xì)胞,促進(jìn)機(jī)體新陳代謝,延緩衰老。
因此,免疫細(xì)胞對身體的健康非常重要!
推薦閱讀:癌癥的天敵,最好的醫(yī)生— NK細(xì)胞療法

白細(xì)胞(WBC)
白細(xì)胞是一類免疫細(xì)胞的統(tǒng)稱。白細(xì)胞分很多種:有淋巴細(xì)胞,粒細(xì)胞,單核細(xì)胞,巨噬細(xì)胞。其中粒細(xì)胞又可以分為嗜酸性粒細(xì)胞,嗜中性粒細(xì)胞和嗜堿性粒細(xì)胞。
當(dāng)細(xì)菌,病毒,寄生蟲等有害微生物侵入人體后,白細(xì)胞會增殖,分化,成熟,來消滅這些有害物質(zhì),在殺滅這些有害微生物的同時(shí),白細(xì)胞自己也會犧牲。除了抵抗外敵入侵,白細(xì)胞還負(fù)責(zé)消滅體內(nèi)老化的,死亡的,有病變的,癌變的細(xì)胞和組織。

特種兵——T細(xì)胞
作為白細(xì)胞的一種,T細(xì)胞有著不可替代的作用,它們就像人體里面的特種兵,戰(zhàn)斗力十足。

它們在人體的骨髓里出生,然后,它們會前往人體的胸腺,在那里接受一段時(shí)間的“訓(xùn)練”。當(dāng)再次走出胸腺時(shí),它們就成了一個(gè)個(gè)可以隨時(shí)出征的特種兵。
推薦閱讀:科普 | 免疫細(xì)胞主要有什么功能和作用?
T細(xì)胞不像其他白細(xì)胞那樣,只要是病毒,就不管三七二十一,一起上去群毆。T細(xì)胞可是有選擇地出擊,對付一種特定的病毒,人體的無數(shù)個(gè)T細(xì)胞中,通常只有一個(gè)T細(xì)胞會作出反應(yīng)。人家真是做到了精準(zhǔn)打擊!
聯(lián)絡(luò)兵——樹突狀細(xì)胞(DC)
樹突狀細(xì)胞外形獨(dú)特,就像一個(gè)個(gè)張牙舞爪的樹妖。平時(shí),它們就像巡邏兵一樣,在身體各處到處轉(zhuǎn)悠。一旦發(fā)現(xiàn)病毒,它們就會猛撲上去,將其迅速吞食,之后在體內(nèi)對這個(gè)病毒進(jìn)行加工,提取病毒的特征“碎片”,并把這個(gè)碎片扛在自己肩上,然后,它們開始長途跋涉,去尋找并聯(lián)絡(luò)可以對付這種病毒的T細(xì)胞。

樹突狀細(xì)胞在身體內(nèi)的這種神奇功能,是被一個(gè)叫拉爾夫·斯坦曼的科學(xué)家首先發(fā)現(xiàn)的。2011年10月3日,瑞典卡羅琳醫(yī)學(xué)院宣布,拉爾夫·斯坦曼獲得2011年諾貝爾生理學(xué)或醫(yī)學(xué)獎的一半獎金,另一半獎金由另外兩個(gè)科學(xué)家共同獲得。他們?nèi)坏难芯?,發(fā)現(xiàn)了免疫系統(tǒng)激活的關(guān)鍵原理,從而徹底革新了人類對免疫系統(tǒng)的認(rèn)識。
導(dǎo)彈庫——B細(xì)胞
B細(xì)胞,胖胖的身軀裝滿了消滅病原體的“導(dǎo)彈”——抗體。當(dāng)遇到病原體或者是癌細(xì)胞的時(shí)候,它們將會被T細(xì)胞激活,然后第一時(shí)間分裂自己,復(fù)制出大量的B細(xì)胞并且制造數(shù)以萬計(jì)的抗體。

接著就開始發(fā)射身體里面的“導(dǎo)彈”啦!它們隨著身體噴涌而出,將敵人通通消滅。一秒鐘內(nèi),一個(gè)B細(xì)胞大約能發(fā)射2000發(fā)“導(dǎo)彈”!而這些導(dǎo)彈,學(xué)名叫抗體。
衛(wèi)士——自然殺傷細(xì)胞(NK)
自然殺傷細(xì)胞屬于白細(xì)胞的一種,它是人體忠誠的衛(wèi)士,主要任務(wù)就是亡羊補(bǔ)牢——消滅那些已經(jīng)被病毒感染的細(xì)胞,從而把病毒消滅在“搖籃”中。

另外,身體里面的腫瘤細(xì)胞也是它們追殺的對象。自然殺傷細(xì)胞使用的武器就是“穿孔素”,當(dāng)它把穿孔素“噴在”細(xì)胞上時(shí),能在細(xì)胞上打一個(gè)小洞,從而消滅細(xì)胞,連帶消滅里面的病毒。
單核細(xì)胞
單核細(xì)胞是血液中最大的血細(xì)胞,像孫悟空一樣,它會變身,而且,運(yùn)動能力也很強(qiáng),能從血液中離家出走。它不光能吞噬病菌,還能清除受傷和衰老的細(xì)胞及其碎片。
推薦閱讀:干細(xì)胞和免疫細(xì)胞強(qiáng)強(qiáng)聯(lián)手,共同“殺敵”

如果身體里某個(gè)地方出現(xiàn)了炎癥,那么,單核細(xì)胞的活兒就來了,它會在8到12小時(shí)內(nèi),快速聚集到感染組織。
人體清道夫——巨噬細(xì)胞
當(dāng)單核細(xì)胞從血液中離家出走,來到血管外,到身體的其他組織中時(shí),單核細(xì)胞的體積會增大,直徑可達(dá)50~80微米,這時(shí),它就不叫單核細(xì)胞了,它變成了一個(gè)更加強(qiáng)大的人體斗士——巨噬細(xì)胞!

巨噬細(xì)胞是人體的清道夫,一直在為我們的身體做清潔工作,它們會吞掉那些進(jìn)入肺里面的細(xì)小塵埃。正是因?yàn)榫奘杉?xì)胞的辛勤勞動,我們的肺才不至于被無數(shù)的塵埃污染。
它還會吞掉那些死去的細(xì)胞,比如死去的紅細(xì)胞等。當(dāng)你受傷了,皮膚內(nèi)的小血管破裂,紅細(xì)胞就會流出血管外。紅細(xì)胞在血管內(nèi)是寶,可在血管外,對我們沒有任何好處,反而會有壞處。但是,不用擔(dān)心,死細(xì)胞的清理工作會由巨噬細(xì)胞來完成。
如果忙不過來,巨噬細(xì)胞還會召喚它的很多同伴,一起來戰(zhàn)斗。作為人體的強(qiáng)大衛(wèi)士,巨噬細(xì)胞可以吞掉大量病菌,最后,它們死于自己分泌的消化混合物。
哨兵——肥大細(xì)胞
這個(gè)胖子是白細(xì)胞的一種,一般都存在于各種于外界接觸的組織之中的(皮膚、呼吸道、消化道、泌尿道等等)。
細(xì)胞表面上有IgE的受體,當(dāng)有相鄰兩個(gè)IgE被外來致敏的抗原結(jié)合后,正好就激活了肥大細(xì)胞這個(gè)放哨的,然后使勁“吹哨”,也就發(fā)生脫顆粒(degranulation),給周圍的神經(jīng)、血管和細(xì)胞釋放警示信號。
推薦閱讀:干細(xì)胞是“+”,修復(fù)、替換、激活;免疫細(xì)胞是“-”,清除、代謝

“殺手”——中性粒細(xì)胞
它是哺乳動物血液中最主要的白細(xì)胞,來源于骨髓,生成很快,但只能存活兩三天。它在非特異性免疫系統(tǒng)中起著非常重要的作用。
中性粒細(xì)胞的殺傷能力非常強(qiáng),“膿細(xì)胞”這個(gè)詞就是說它。它能夠把體內(nèi)的組織細(xì)胞直接干死變成一包液體(膿液)。
淋巴細(xì)胞
淋巴細(xì)胞核圓,核占比較大,所以鏡下像個(gè)球。它是白細(xì)胞中體積最小的一種,主要由淋巴器官產(chǎn)生,是一類具有免疫識別功能的細(xì)胞系。

淋巴細(xì)胞在適應(yīng)性免疫中起關(guān)鍵作用,經(jīng)血液和淋巴液周游全身,將淋巴器官和其他器官的淋巴組織連成一個(gè)功能整體,使免疫系統(tǒng)具備識別和記憶抗原能力,從而識別和清除微生物、異體細(xì)胞或大分子物質(zhì),并監(jiān)護(hù)我們身體內(nèi)部穩(wěn)定性,清除表面抗原發(fā)生變化的細(xì)胞。
寫在最后
人類正是因?yàn)橛羞@些免疫細(xì)胞的存在,才能夠在幾千年,甚至是幾萬年的進(jìn)化史中一躍成為食物鏈的頂端“玩家”。有了免疫系統(tǒng),我們才能夠避免世間很多病毒的侵襲,才能夠避免很多疾病,因此心存感激,感謝一下整日為了你的健康而不斷運(yùn)轉(zhuǎn)的免疫細(xì)胞吧!只有“內(nèi)安”才能“攘外”!
魯公網(wǎng)安備37010002000272號